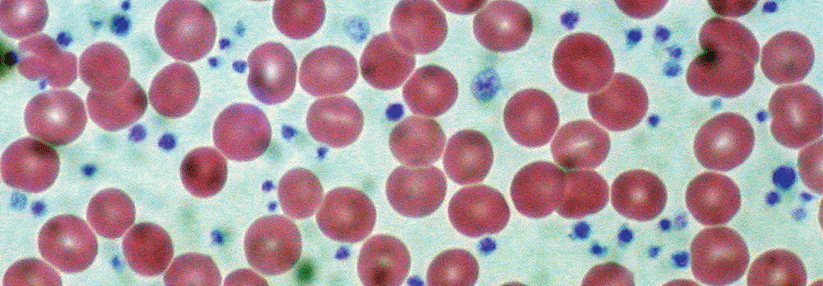

Thrombozytosen mit drei einfachen Tests abklären
 In diesem Fall sind es 1,5 Millionen Plättchen pro µl. Der Patient ist symptomfrei.
© wikimedia/Ed Uthman
In diesem Fall sind es 1,5 Millionen Plättchen pro µl. Der Patient ist symptomfrei.
© wikimedia/Ed Uthman
Von einer Thrombozytose spricht man, wenn die Zahl der Blutplättchen 400 000–450 000/µl übersteigt. Dieser Befund liegt bei etwa 2–3 % der Bevölkerung vor, schreibt das Team um Dr. Abhinav Mathur von der School of Medicine & Dentistry der Universität von Aberdeen. Thrombozytosen können die verschiedensten Ursachen haben (s. Kasten). Reaktive Formen werden durch die Freisetzung thrombopoetischer Wachstumsfaktoren getriggert, klonale durch die Expansion mutierter hämatopoetischer Stammzellen.
Was feuert die Plättchen an?
- reaktive Thrombozytose: Eisenmangel, Infektion, Entzündungen (v.a. Rheuma), kurz zurückliegende OP oder Trauma, Tumor, Z.n. Splenektomie, Blutverlust, Medikamente etc.
- klonale Thrombozytose: Myeloproliferative Neoplasie (z.B. essenzielle Thrombozythämie, Polycythaemia vera, primäre Myelofibrose, chronisch myeloische Leukämie), oder andere Knochenmarkerkrankungen (z.B. chronisch myelomonozytäre Leukämie, Myelodysplasie)
- andere Ursachen: hereditäre Thrombozytose, Anomalien der roten Reihe, falsche Thrombozytose
Die Beschwerden korrelieren nicht mit der Plättchenzahl
Diagnostisch stehen wie immer an erster Stelle eine gründliche Anamnese und klinische Untersuchung. Viele Auslöser reaktiver Zellanstiege lassen sich damit bereits identifizieren. Die meisten Patienten mit klonaler Erkrankung sind dagegen asymptomatisch. Manche klagen über vasomotorische Symptome (Kopfschmerz, Sehstörungen etc.), andere haben Blutungen oder thrombotische Komplikationen. Fatigue und Pruritus können auf myeloproliferative Erkrankungen hindeuten, aber es gibt keine klare Korrelation zwischen Beschwerden und Plättchenzahl. Für die initiale Labordiagnostik genügen:1. Der Ausstrich von peripherem Blut bestätigt eine echte Thrombozytose und schließt eine falsche aus. Eine Linksverschiebung spricht für eine Infektion. Auch eine abnorme Morphologie weist manchmal den Weg, beispielsweise sieht man große Plättchen bei der essenziellen Thrombozythämie. Eine begleitende Polycythämie oder Leukozytose weckt den Verdacht auf eine klonale Erkrankung. 2. Ein erhöhtes CRP und eine beschleunigte Blutsenkung signalisieren eine reaktive Thrombozytose. Normale Werte schließen eine Entzündung oder ein Malignom jedoch nicht aus. 3. Auf Stufe drei steht der Eisenstatus: Schließlich ist die Eisenmangelanämie eine behandelbare Ursache der Thrombozytose und ein niedriges Serumferritin bestätigt diese Blutarmut praktisch zu 100 %. Wichtig: die Plättchenkontrolle. Rückbildung oder Persistenz der Vermehrung lässt sich mit einem erneuten Blutbild einfach eruieren. Die Autoren empfehlen allerdings, mit der Wiederholung des Blutbilds mehr als drei Monate zu warten. Dass dies meist gefahrlos geht, zeigt eine italienische Studie mit 10 000 asymptomatischen Patienten. Weniger als 10 % der Teilnehmer hatten nach acht Monaten noch eine Thrombozytose und nur zwei Probanden eine Polycythaemia vera.
Blutanomalie als Hinweis auf Lungen- oder Kolonkarzinome
Bei den meisten Betroffenen gelingt es, den Auslöser durch eine klinische Untersuchung zu ermitteln. Zu beachten ist jedoch, dass auch subklinische Erkrankungen reaktive Thrombozytosen verursachen können. Eine frühe Diagnostik könnte also zum Beispiel die zeitige Detektion eines Malignoms ermöglichen. Dies bestätigt eine Studie mit 1200 Patienten unter 40 Jahren. Bei einem Drittel entdeckte man im Zuge der Bluterkrankung ein Lungen- oder Kolonkarzinom, das bisher keine Symptome verursacht hatte. Diese Kranken wären ohne die Abklärung des pathologischen Blutbilds nicht zum Spezialisten geschickt worden. Im Falle persistierender Thrombozytosen ohne bekannte Ursache raten die Autoren ausdrücklich dazu, einen Spezialisten hinzuzuziehen. Gleiches gilt, wenn thrombotische Komplikationen vorliegen oder der Verdacht auf eine primär hämatologische Erkrankung besteht. Eine hämatologische Untersuchung sollte auch Tests auf mögliche Treibermutationen umfassen, wie JAK2 V617F, MPL, BCR-ABL und CALR. Etwas für den Fachmann war auch die oben genannte Patientin. Ihre Thrombozytenzahl blieb bei wiederholten Kontrollen erhöht – ohne dass sich Hinweise auf eine Entzündung oder einen Tumor ergeben hätten. Der Hämatologe diagnostizierte schließlich aufgrund einer pathologischen Knochenmarkbiopsie eine essenzielle Thrombozythämie, getrieben von einer JAK2-V617F-Mutation. Das Risiko für thrombotische Komplikationen wurde als intermediär eingestuft. Die Patientin erhielt ein Screening auf kardiovaskuläre Risikofaktoren und startete eine ASS-Therapie. Eine Zytoreduktion mit Hydroxycarbamid war nicht indiziert.Quelle: Mathur A et al. BMJ 2019; 366: L4183; DOI: doi.org/10.1136/bmj.l4183



